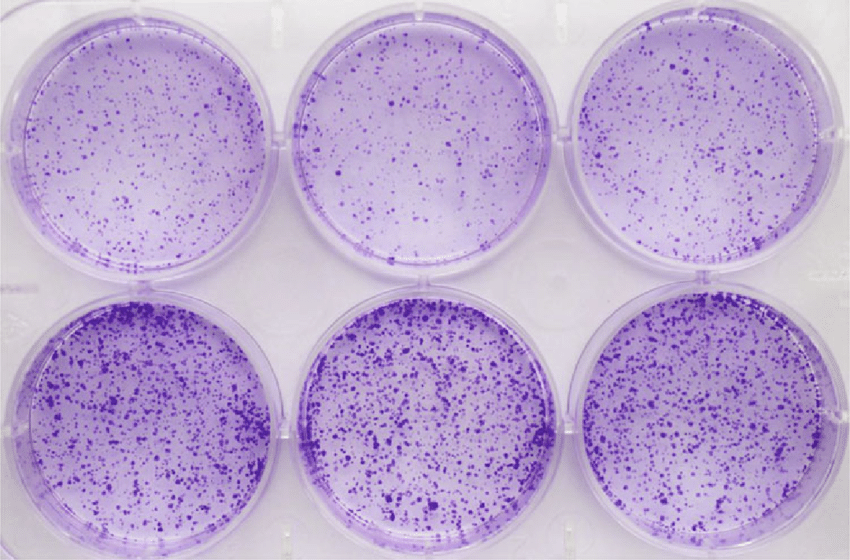
클로노제닉 어세이

-
클로노제닉 어세이란
콜로니 형성 분석으로도 알려진 클론 생성 분석은 개별 세포의 생존, 번식 및 콜로니 형성 능력을 평가하는 데
사용되는 널리 사용되는 시험관 내 세포 생존 분석입니다.
클로노제닉 어세이 (Clonogenic assay)
적용 분야
클론 생성 분석은 방사선, 화학요법, 표적 치료에 대한 암과 정상 세포의 민감도를 평가하고 치료 요법의 임상적 효과를 나타내는 데 사용됩니다.
약물 조합 및 조합 치료법은 상가적, 시너지 효과를 제공하여 보다 효과적인 치료 옵션을 제공할 수 있습니다.
클로노제닉 어세이 방법
두가지 방법이 있습니다.
1) 셀을 낮은 밀도로 seeding 하고 일정 기간 약물을 처리하는 방법,2) 높은 밀도로 seeding 하여 약물을 처리한 후 harvest하여 낮은 밀도로 re-seeding 하는 방법
각각의 방법은 목적에 따라서
첫 번째 방법은 치료의 민감도와 효과를 평가하는 데 사용되며
두 번째 방법은 세포 손상 수리와 치료 저항 조사에 더 많이 사용됩니다.
클로노제닉 어세이 (Clonogenic assay) Protocol
두번째 방법으로 실험을 진행
1. 세포를 Cell plate에 적정농도를 seeding 하여 60% 정도의 confluency로 배양합니다.
2. 목적성에 맞게 약물 및 처리시간을 정한 후 세포에 약물을 처리합니다.
3. 트립신을 이용하여 세포를 harvest 후 정해진 Cell plate에 낮은 농도로 다시 seeding 합니다.
4. 한 콜로니가 50번정도의 증식을 진행하게 되면 실험 종료 시점으로 정합니다.
5. 미디어 제거 후 세포 고정 및 염색을 진행합니다.
6. 0.5% Crystal violet, 20% Methanol을 증류수에 녹입니다.
7. 콜로니가 덮힐 정도의 양을 분주하여 20분간 실온반응을 합니다.
8. 흐르는 수돗물로 염색양을 깨끗이 씻어내고 말려줍니다.
클로노제닉 종류
in vitro에서 목적에 따라 클로니 생성하는 다양한 방법들이 있습니다.
1) 클로노제닉 어세이, 2) 소프트 한천 콜로니 형성, 3) 콜로니 형성 어세이 3가지로 나눌 수 있습니다.
1) 클로노제닉 어세이
세포가 배양접시의 표면에 2D로 부착되며 고정에 의존하는 단분자층 집락 성장을 나타내는 원래의 클론 생성 분석. 정상 세포와 암 세포가 이를 입증할 수 있습니다.
2) 소프트 한천 콜로니 형성
세포는 배지와 혼합된 연질 한천 층에서 자라며 암세포만이 고정된 독립적인 집락 성장을 나타내기 때문에 종양 형성의 최종적인 지표를 의미합니다.
3) 콜로니 형성 어세이
CFC assay는 조혈모세포의 연구에 사용되며, 조혈모세포가 형태학적으로 특징지어질 수 있는 조혈전구세포로 증식 및 분화하는 능력에 기초합니다.'실험 프로토콜' 카테고리의 다른 글
[1편] 그래프패드 프리즘으로 막대그래프 그리는 법 (0) 2025.06.17 cDNA (complementary DNA) 합성 Protocol (0) 2024.06.03 RNA 추출 Protocol 및 원리 (0) 2024.04.03 IC50값 확인과 그래프 간단하게 그리기 (0) 2024.03.31 [Flow cytometry] 세포주기 (Cell cycle) Gating 및 분석 (0) 2024.03.27